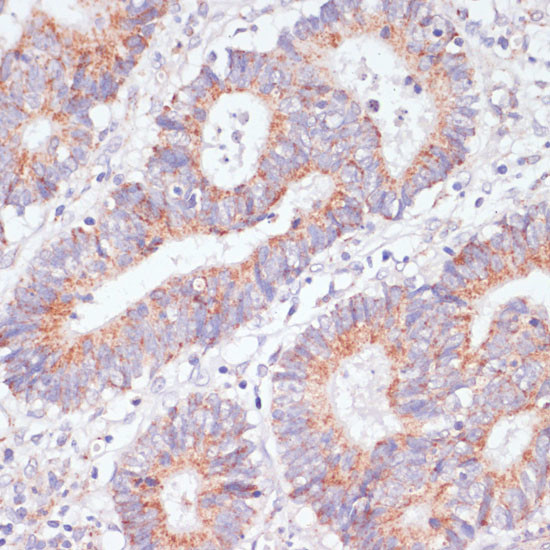
RAP1A Antibody in Immunohistochemistry (Paraffin) (IHC (P))

Search
Invitrogen
RAP1A Polyclonal Antibody
{{$productOrderCtrl.translations['antibody.pdp.commerceCard.promotion.promotions']}}
{{$productOrderCtrl.translations['antibody.pdp.commerceCard.promotion.viewpromo']}}
{{$productOrderCtrl.translations['antibody.pdp.commerceCard.promotion.promocode']}}: {{promo.promoCode}} {{promo.promoTitle}} {{promo.promoDescription}}. {{$productOrderCtrl.translations['antibody.pdp.commerceCard.promotion.learnmore']}}
图: 1 / 6
RAP1A Antibody (PA5-87540) in IHC (P)






Please note: We are reviewing Western blot images included in the antibody testing data in our catalog, including those provided by third parties. Unless expressly labeled or annotated as “raw-unedited”, Western blot images included in the antibody testing data in our catalog may have been edited, optimized or otherwise adjusted for presentation.
产品信息
PA5-87540
种属反应
宿主/亚型
分类
类型
抗原
偶联物
形式
浓度
规格
纯化类型
保存液
内含物
保存条件
运输条件
RRID
产品详细信息
Positive Samples: U-87MG, HL-60, Mouse lung, Mouse kidney, Rat kidney, Rat brain; Cellular Location: Cell junction, Cell membrane, Cytoplasm, Early endosome, Lipid-anchor, perinuclear region
Immunogen sequence: SYRKQVEVDC QQCMLEILDT AGTEQFTAMR DLYMKNGQGF ALVYSITAQS TFNDLQDLRE QILRVKDTED VPMILVGNKC DLEDERVVGK EQGQNLARQW
靶标信息
The product of this gene belongs to the family of RAS-related proteins. These proteins share approximately 50% amino acid identity with the classical RAS proteins and have numerous structural features in common. The most striking difference between RAP proteins and RAS proteins resides in their 61st amino acid: glutamine in RAS is replaced by threonine in RAP proteins. The product of this gene counteracts the mitogenic function of RAS because it can interact with RAS GAPs and RAF in a competitive manner. Two transcript variants encoding the same protein have been identified for this gene.
仅用于科研。不用于诊断过程。未经明确授权不得转售。